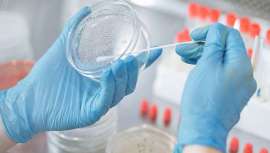
A pesar de ser un país pionero en el cruelty free, hace ahora 25 años, Reino Unido da un paso atrás al permitir el testado en animales en algunos contextos

-
Una evolución con un amplio futuro
-
Pterostilbeno, un activo natural que convence a la ciencia antiedad
Un nuevo estudio clínico revela que el pterostilbeno ofrece una eficacia antiedad superior incluso a las fórmulas de control
-
Luz Pulsada Intensa: ciencia, estética y la nueva era del rejuvenecimiento facial
Aunque muchas personas asocian la IPL con la eliminación del vello, su potencial va mucho más lejos. La nueva ola de dispositivos IPL integra innovaciones para hacer las sesiones más rápidas, seguras y cómodas
-
Una navidad de alta costura: los nuevos cofres de Bruno Vassari
Bruno Vassari celebra la temporada con cofres de edición limitada que elevan el arte de regalar con estilo y sofisticación
-
CONCURSO BEAUTY MARKET ESTÉTICA
Beauty Market y mesoestetic® regalan 6 packs de productos mesoprotech®, protección solar de amplio espectro y máxima eficacia
Tecnologías avanzadas y nuevos formatos que facilitan la aplicación y maximizan la eficacia de sus productos
Se han obtenido 3661 artículos en TOTAL. Mostrando del 541 al 600